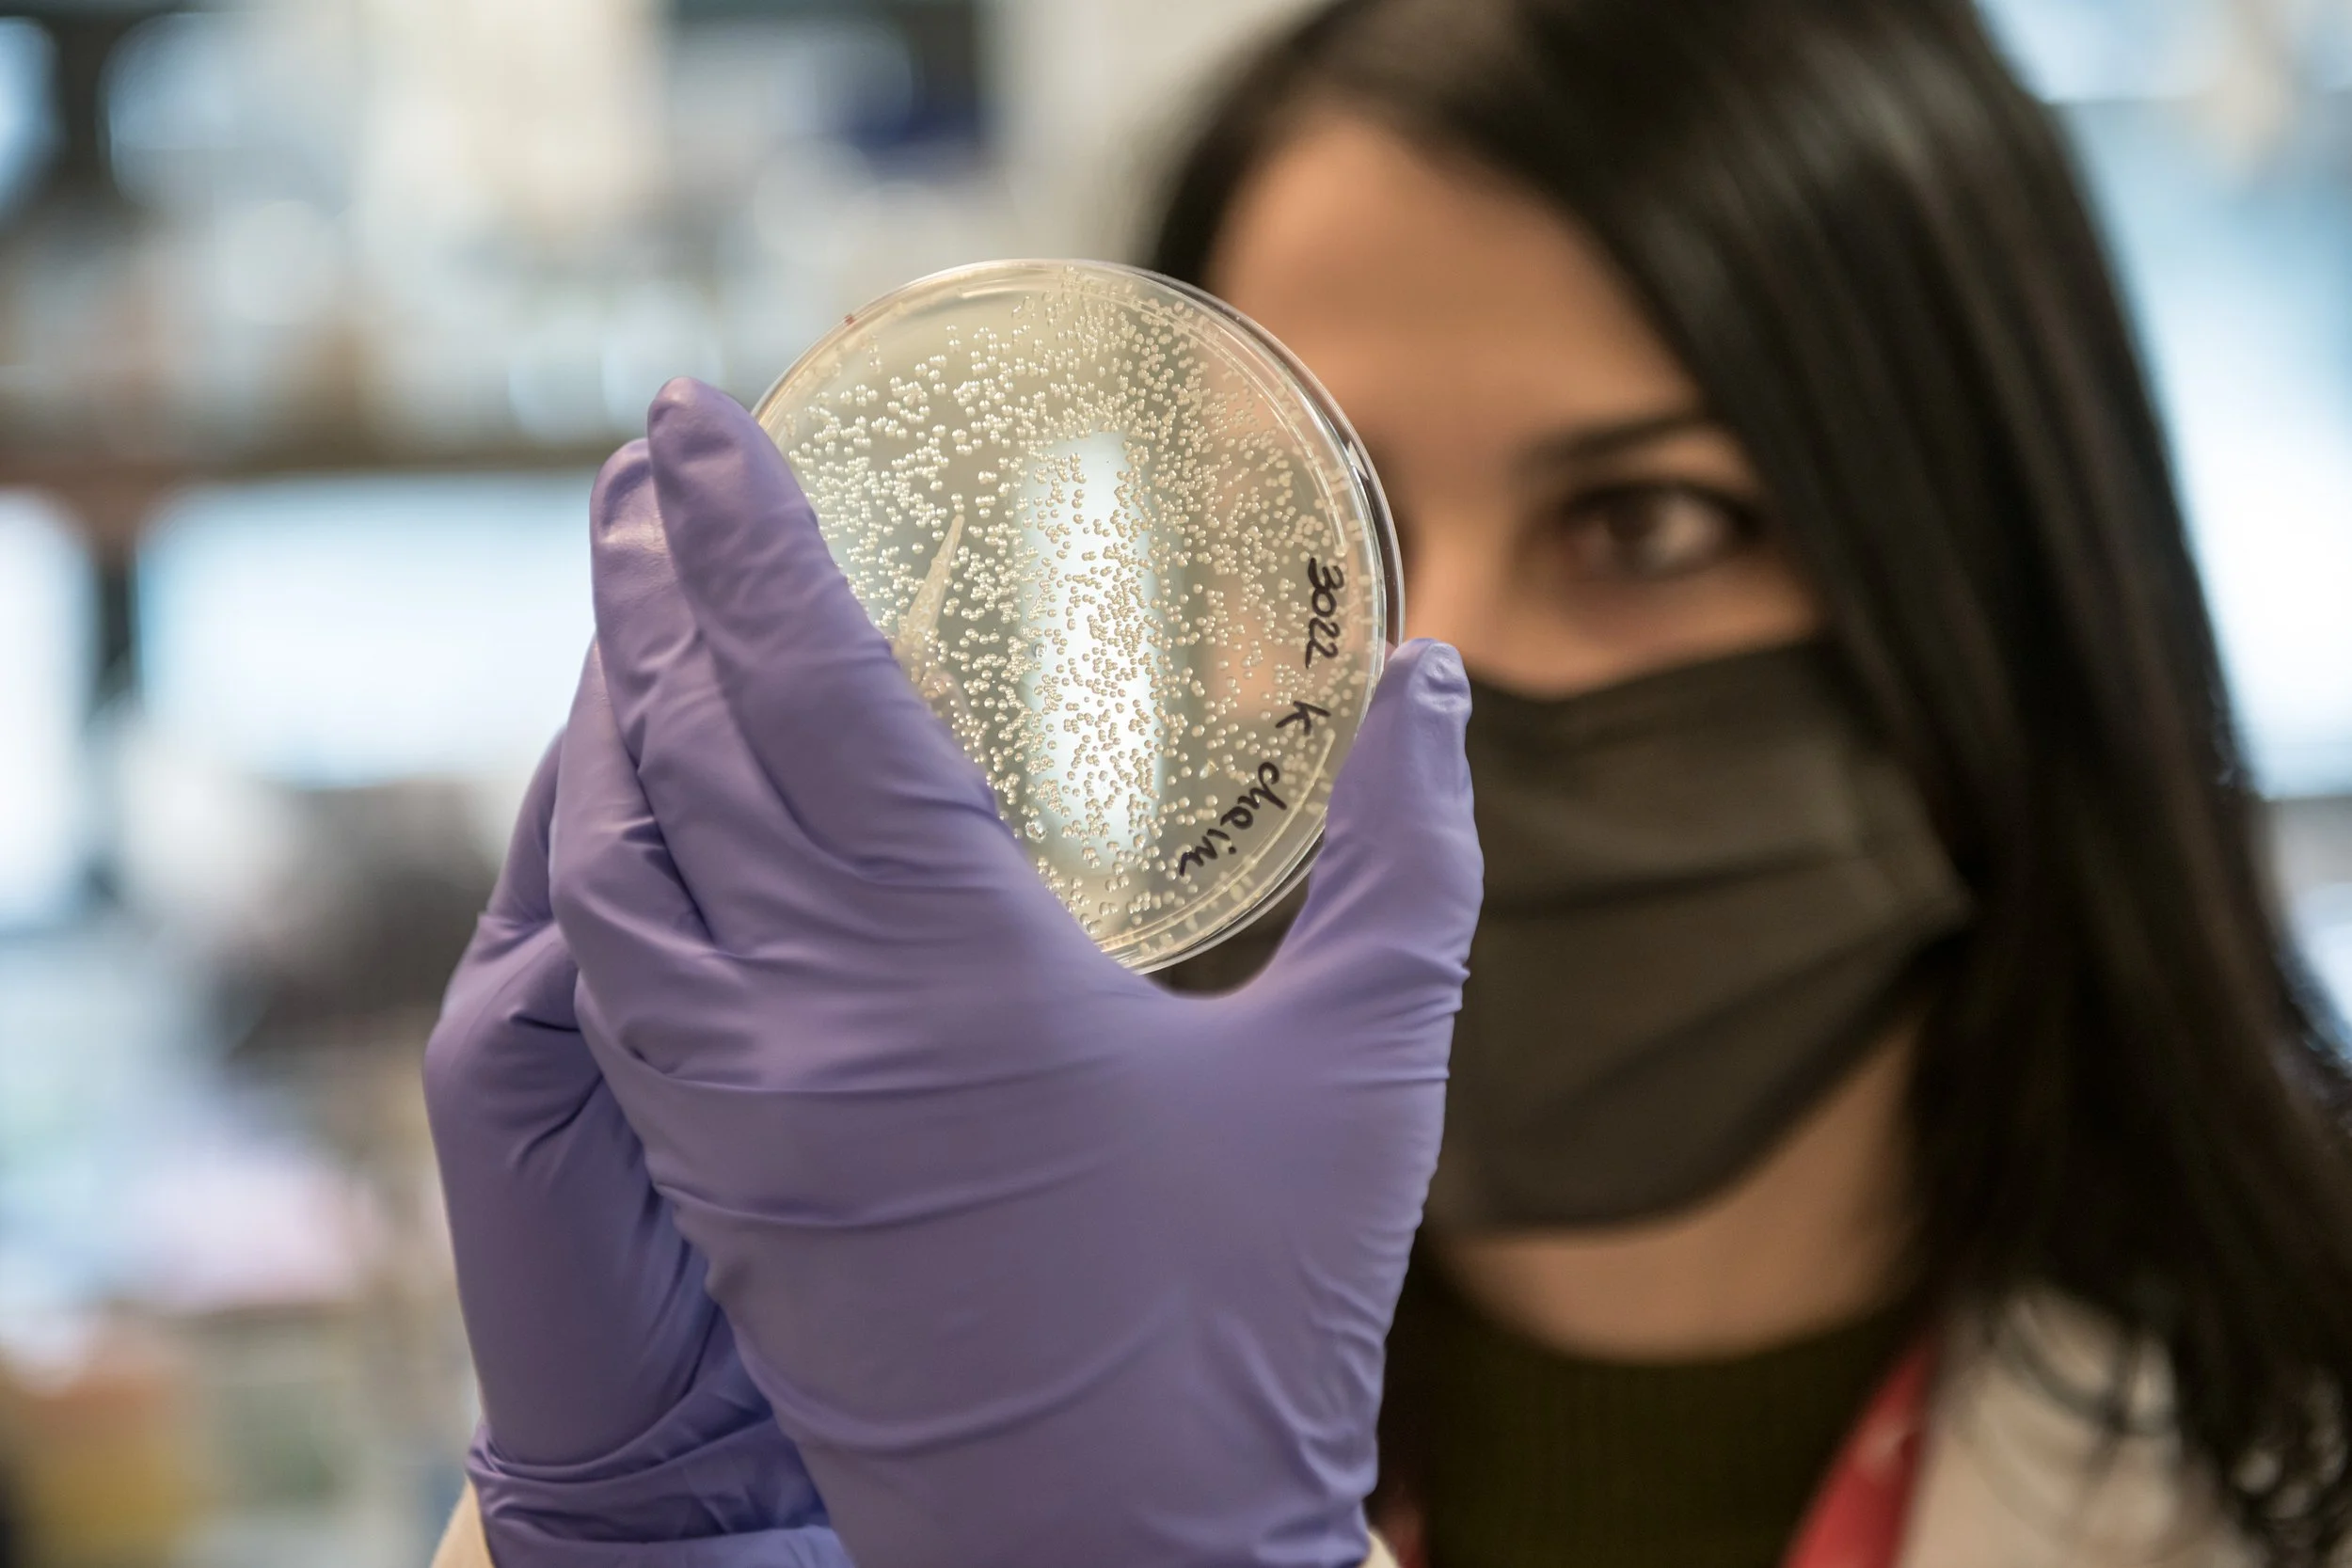
ToscanaLIfeScience_0274.jpeg

Covid Vaccine Chain
The Vaccine Production Chain Manufacturing, storage, transport, and refrigeration, not to mention scientific research. On the frontline against Covid-19 can be found a world that is all Italian. An extensive production chain composed of diverse businesses is engaged in the fight against the pandemic, beginning with scientific research and moving through transport, storage, and the extraction of carbon dioxide to produce dry ice for refrigeration, to the manufacture of syringes for administering the vaccine. This world is little known but spans from Triveneto to Campania, Piedmont to Tuscany, taking in Lazio and Abruzzo. The common goal is to complete the vaccine plan to immunize the majority of the population as quickly as possible. A fight against time that begins at the laboratories of the biotech company ReiThera, engaged in the production of the first all-Italian vaccine, and in those of the Fondazione Toscana Life Science, which is working to develop monoclonal antibodies to respond to the virus. But there are also large and small firms of acknowledged excellence, such as Bormioli in Parma, Desmon in Avellino, Ceam in Florence, Melform in Cuneo and many, many others.